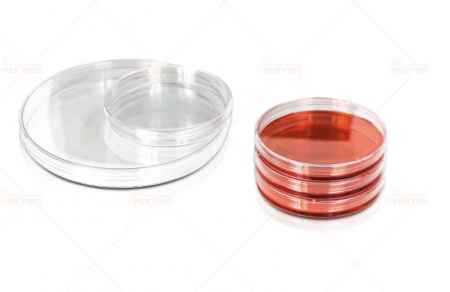
ЧАШКИ ПЕТРИ, PS, 150 ММ Х 15 ММ, 143СМ2, СТЕРИЛЬНЫЕ 200/УП, PK00271 PEKYBIO

товар и нажмите кнопку «В корзину». Перейти в каталог
товар и нажмите кнопку «В избранное». Перейти в каталог
Для покупки товара в нашем интернет-магазине выберите понравившийся товар и добавьте его в корзину. Далее перейдите в Корзину и нажмите на «Оформить заказ» или «Быстрый заказ».
Когда оформляете быстрый заказ, напишите ФИО, телефон и e-mail. Вам перезвонит менеджер и уточнит условия заказа. По результатам разговора вам придет подтверждение оформления товара на почту или через СМС. Теперь останется только ждать доставки и радоваться новой покупке.
Оформление заказа в стандартном режиме выглядит следующим образом. Заполняете полностью форму по последовательным этапам: адрес, способ доставки, оплаты, данные о себе. Советуем в комментарии к заказу написать информацию, которая поможет курьеру вас найти. Нажмите кнопку «Оформить заказ».
Экономьте время на получении заказа. В интернет-магазине доступно 4 варианта доставки:
Экономьте время на получении заказа. В интернет-магазине доступно 4 варианта доставки:
Мы используем файлы cookie, разработанные нашими специалистами и третьими лицами, для анализа событий на нашем веб-сайте, что позволяет нам улучшать взаимодействие с пользователями и обслуживание. Продолжая просмотр страниц нашего сайта, вы принимаете условия его использования. Более подробные сведения смотрите в нашей Политике в отношении файлов Cookie.
